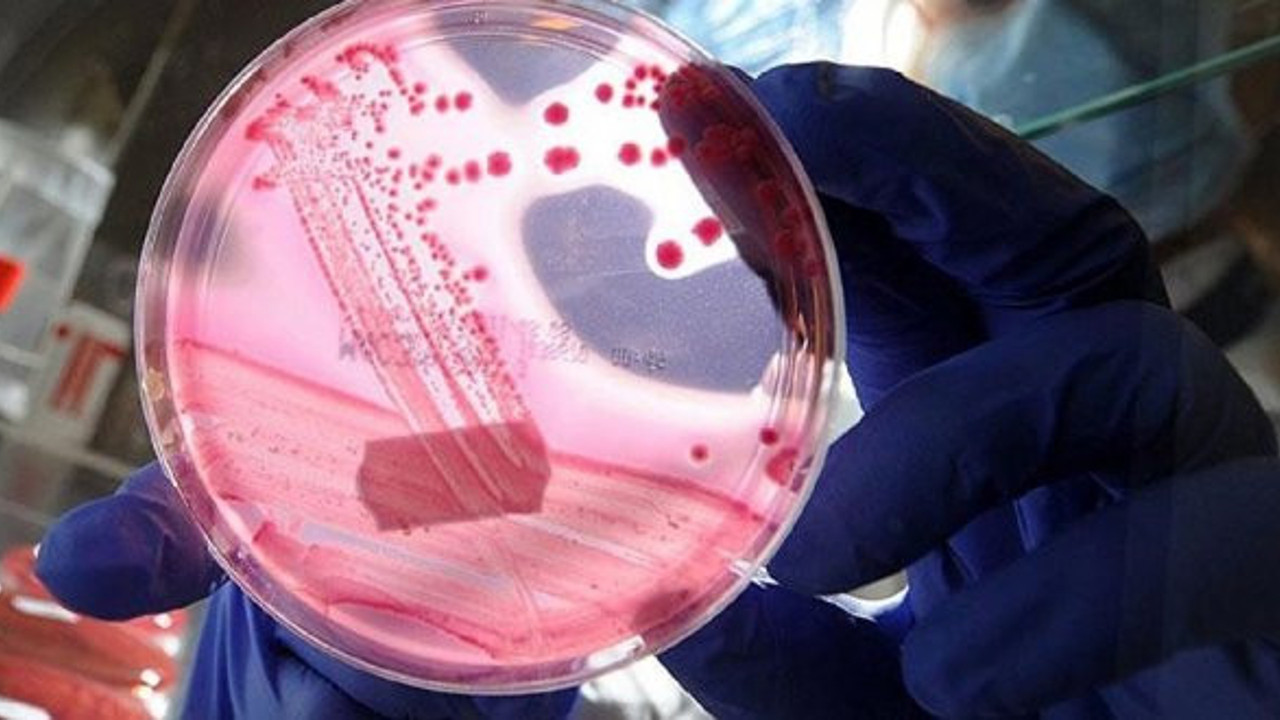
‘Genetik tasarımlı bebekler’ dünyaya geldi

Yedi kadının tüp bebek tedavisi sırasında bazı embriyoların genetiğinin değiştirildiği ve hamilelikle sonuçlanan ilk denemede ikiz kız bebeklerin dünyaya geldiği açıklandı.
He, embriyolardaki bu deneyleri, vücuda AIDS virüsü HIV'e karşı bağışıklık kazandırmak amacıyla yaptığını söyledi.
Uzmanlar, He'nin açıklamasının doğrulanması halinde bunun genetik bilimi ve etik açısından yeni bir dönem başlatacağını söylüyor.
BİRÇOK ÜLKEDE YASAK
Bazı uzmanlar da "insan deneyi" olarak niteledikleri bu denemelerin çok riskli olduğunu söylüyor.
Genetik tasarım, birçok ülkede DNA'da yapılacak değişikliklerin gelecek nesillere aktarılabileceği ve diğer genlere zarar verilebileceği endişesiyle yasaklanmış durumda.
He'nin iddiası henüz bağımsız kaynaklar tarafından doğrulanmadı. Ancak deneylere ABD'li bir doktorun da katıldığı belirtiliyor.
ABD'de bu tür deneyler yasakken, insan klonlamanın yasak olduğu Çin'de genetik tasarım araştırmaları için bir sınırlama bulunmuyor.